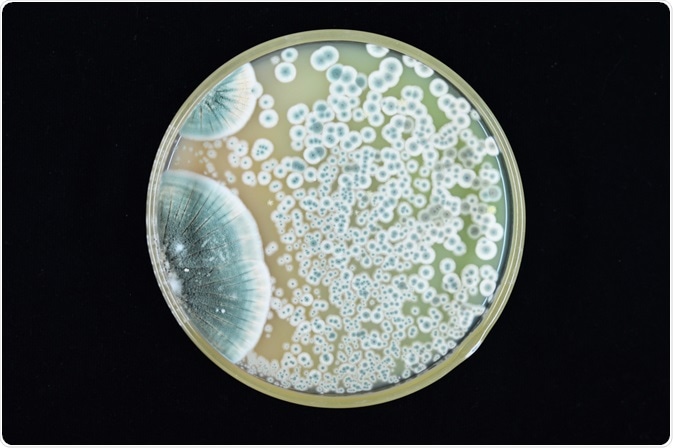
Image Credit: Kallayanee Naloka / Shutterstock

The discovery of penicillin and the scope of its possible usage is arguably the most important scientific discovery of the 20th century. The globalization of penicillin in the years immediately after the Second World War was swift, visible and interesting, and made this important antimicrobial drug both a political and a medical resource.

Image Credit: Fahroni / Shutterstock
Discovery of penicillin
In 1928, Alexander Fleming was studying the growth and characteristics of staphylococci, a type of round-shaped bacteria. In one of his uncovered Petri dishes, airborne spores from a bluish-greenish mold from a genus Penicillium settled in and formed a large colony, which then spread out in a circle and set about dissolving the staphylococci.
This unforeseen event prompted Fleming to investigate the mold that was so effective in attacking the bacteria. In that same year, he isolated and cultivated this fungus in a liquid medium, and found an active substance in the broth. Fleming named the contaminated fungus Penicillium rubrum (later correctly identified as Penicillium notatum), which was the reason for naming the active substance penicillin.
Image Credit: Kallayanee Naloka / Shutterstock
Fleming’s penicillin paper was published in 1929 in the British Journal of Experimental Pathology, and the discovery was largely ignored until scientists at Oxford University recognized its importance in the early 1940s. Howard Florey from the William Dunn School of Pathology, a Cambridge biochemist Norman Heatley and Edward Abraham conducted exploratory research on how penicillin could be used to treat infections.
The publication of the Oxford report on the isolation of various types of bacteria with penicillin coincided with the battles of the Second World War. The first recipient of the penicillin for treating purposes was a police officer, Albert Alexander, who developed a life-threatening infection with huge abscesses after he had scratched the side of his mouth.
Further development
At the Radcliff Infirmary, between February and June 1941, many rooms that have been emptied due to deficiency of research funds at the William Dunn School of Pathology were transformed into penicillin factories. Still, the produced amounts were low, so one of the tasks was to re-isolate penicillin from the urine of patients.
The following step was to get adequate funding from pharmaceutical companies in order to increase production. With the support of the Rockefeller Foundation, Florey and his colleague Norman Heatley traveled to the United States in the summer of 1941 to see whether there was any interest from the American pharmaceutical industry to produce penicillin on a large scale.
Their efforts were a success; penicillin production using fermentation began to increase dramatically by early 1944, while the production of the drug in the United States jumped from 21 billion units in 1943, to more than 6.8 trillion units by1945. By the early 1950s, the major pharmaceutical company, Pfizer, was the largest producer of natural penicillin in the world.
Synthesizing penicillin
The effort to synthesize penicillin during the war was undoubtedly one of the most intensive undertakings in the history of inorganic chemistry. Although the natural fermentation process was satisfyingly used to produce penicillin, the production of synthetic penicillin was elusive.
After the war, chemist John Sheehan from the Massachusetts Institute of Technology pioneered synthetic penicillin in 1957 and first to use the term 'antibiotic'. His work opened the door for the creation of different, bacteria-specific penicillin drugs. Research still continues today in penicillin and related beta-lactam antibiotics.
Further Reading
Last Updated: Feb 25, 2023